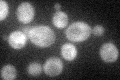
YER088C
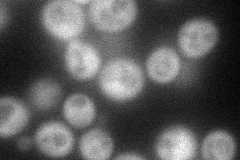
YER088C
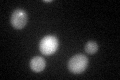
YER088C

View description
Protein involved in rRNA and ribosome biogenesis; binds polymerase A and C motif; subunit of the RPD3L histone deacetylase complex; similar to Tod6p; has chromatin specific SANT domain; involved in telomeric gene silencing and filamentation
Localization:
Intensity:
Fold change:
Significance:
-
C’ GFP library in SD
cytosol37.56 -
N' NOP1pr-GFP in SD
cytosol58.8635 -
N' TEF2pr-mCherry in SD

cytosol66.2725 -
N' NATIVEpr-GFP in SD

below threshold23.3457 -
N' TEF2pr-VC and Cyto-VN in SD

below threshold22.8671 -
C’ GFP library in SD+DTT
cytosol32.840.87No -
C’ GFP library in SD+H2O2

cytosol36.930.98No -
C’ GFP library in Starvation Media

cytosol18.770.49No -
C’ GFP library on the background of Pup2-DaMP

cytosol -
C’ GFP library on the background of CCT mutant

cytosol51.06061.35934Yes
